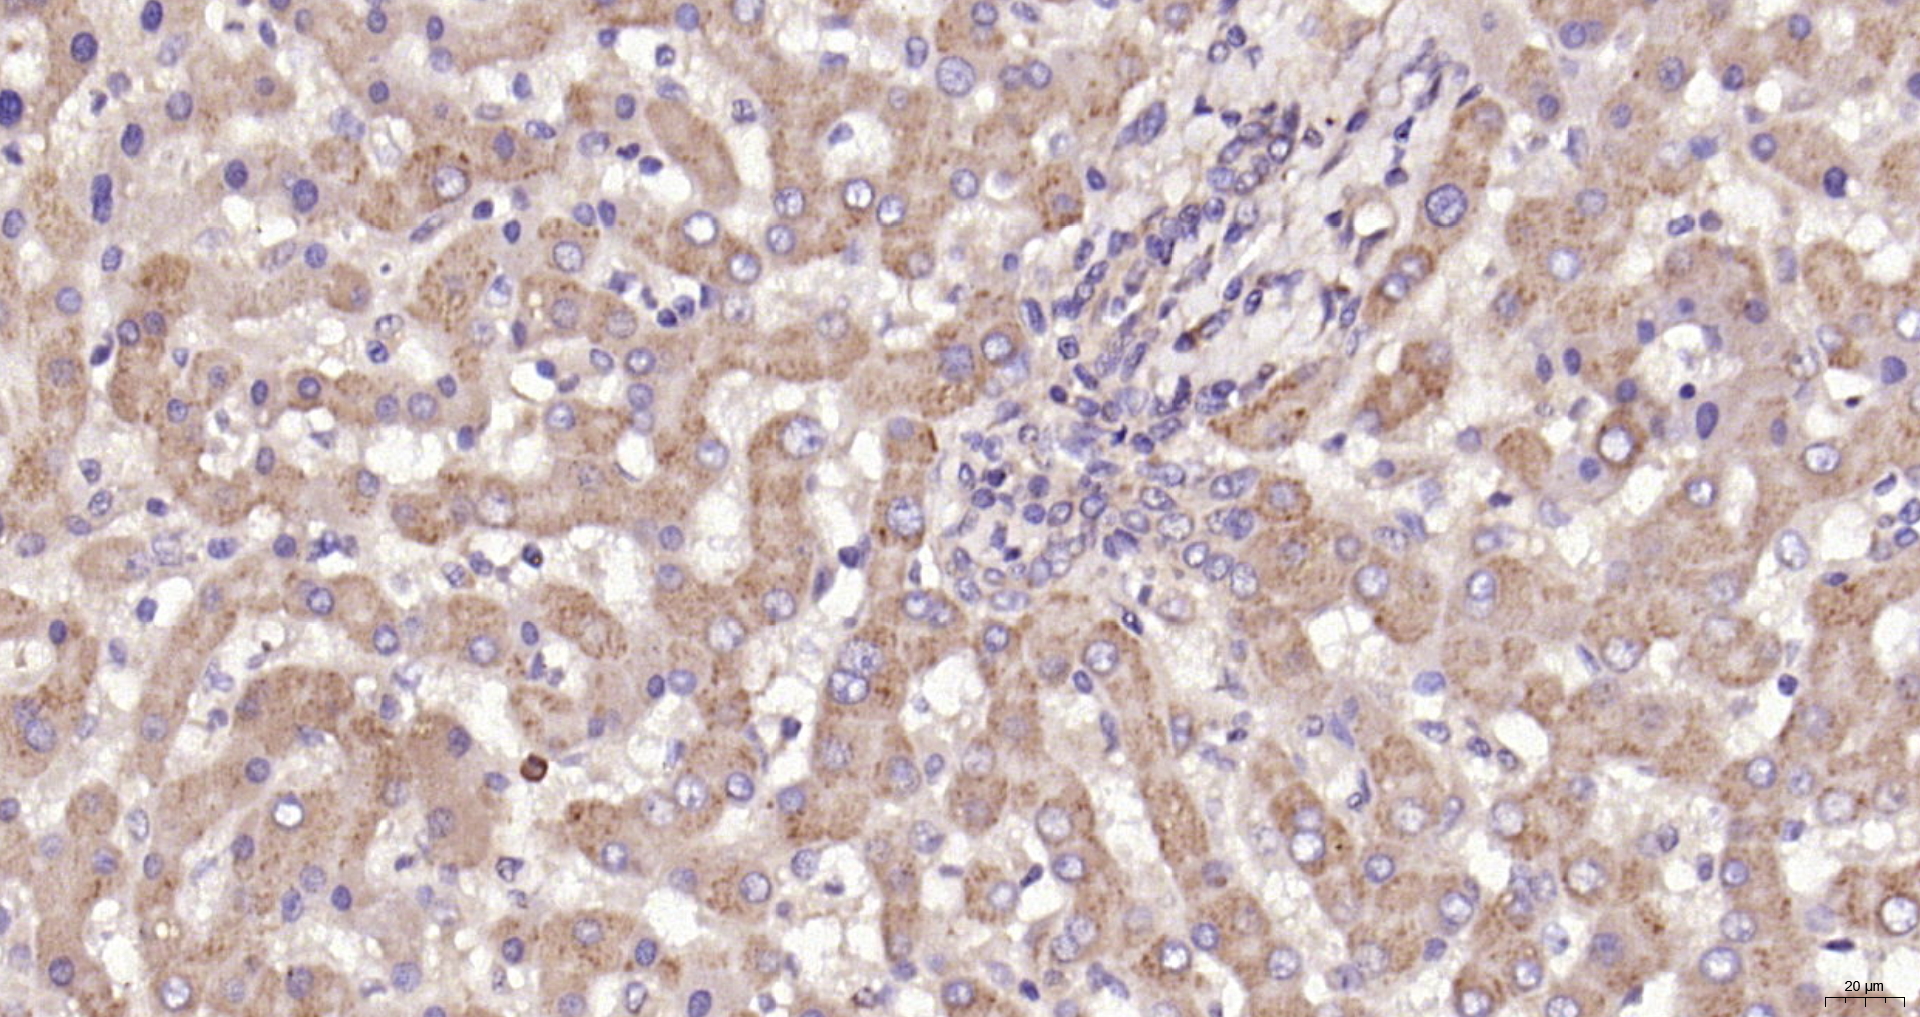
Paraformaldehyde-fixed, paraffin embedded (Human liver ); Antigen retrieval by boiling in sodium citrate buffer (pH6.0) for 15min; Block endogenous peroxidase by 3% hydrogen peroxide for 20 minutes; Blocking buffer (normal goat serum) at 37°C for 30min; Antibody incubation with (Ceramide glucosyltransferase) Polyclonal Antibody, Unconjugated (bs-0701R) at 1:200 overnight at 4°C, followed by operating according to SP Kit(Rabbit) (sp-0023) instructionsand DAB staining.

Mouse splenocytes probed with Rabbit Anti-Ceramide glucosyltransferase Polyclonal Antibody, Unconjugated (bs-0701R) (green) at 1:50 for 30 minutes followed by a FITC conjugated secondary antibody compared to unstained cells (blue), secondary only(light blue), and isotype control(orange).
Ceramide glucosyltransferase Polyclonal Antibody
BS-0701R
ApplicationsFlow Cytometry, ImmunoFluorescence, Western Blot, ELISA, ImmunoCytoChemistry, ImmunoHistoChemistry, ImmunoHistoChemistry Frozen, ImmunoHistoChemistry Paraffin
Product group Antibodies
ReactivityBovine, Human, Mouse, Rat
TargetUGCG
Overview
- SupplierBioss
- Product NameCeramide glucosyltransferase Polyclonal Antibody
- Delivery Days Customer16
- ApplicationsFlow Cytometry, ImmunoFluorescence, Western Blot, ELISA, ImmunoCytoChemistry, ImmunoHistoChemistry, ImmunoHistoChemistry Frozen, ImmunoHistoChemistry Paraffin
- Applications SupplierWB(1:300-5000), ELISA(1:500-1000), FCM(1:20-100), IHC-P(1:200-400), IHC-F(1:100-500), IF(IHC-P)(1:50-200), IF(IHC-F)(1:50-200), IF(ICC)(1:50-200)
- CertificationResearch Use Only
- ClonalityPolyclonal
- Concentration1 ug/ul
- ConjugateUnconjugated
- Gene ID7357
- Target nameUGCG
- Target descriptionUDP-glucose ceramide glucosyltransferase
- Target synonymsGCS, GLCT1, ceramide glucosyltransferase, UDP-glucose:N-acylsphingosine D-glucosyltransferase, glucosylceramide synthase, glycosylceramide synthase
- HostRabbit
- IsotypeIgG
- Protein IDQ16739
- Protein NameCeramide glucosyltransferase
- ReactivityBovine, Human, Mouse, Rat
- Storage Instruction-20°C
- UNSPSC41116161
References
- TBHQ Alleviated Endoplasmic Reticulum Stress-Apoptosis and Oxidative Stress by PERK-Nrf2 Crosstalk in Methamphetamine-Induced Chronic Pulmonary Toxicity. Wang Y et al., 2017, Oxid Med Cell LongevRead this paper